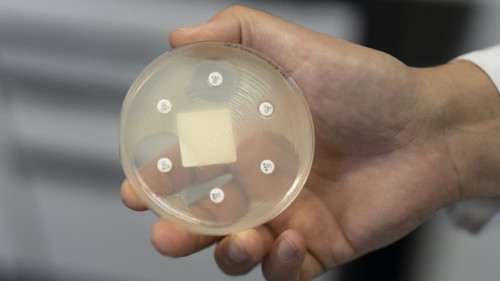

Julien Sprunger: "Ce shoot est parti au bon endroit"
Auteur du but décisif en prolongation, le capitaine fribourgeois a offert mercredi la victoire aux Dragons lors de l’acte 3 de la finale. Ils mènent désormais 2-1 dans la série.
Auteur du but décisif en prolongation, le capitaine fribourgeois a offert mercredi la victoire aux Dragons lors de l’acte 3 de la finale. Ils mènent désormais 2-1 dans la série.
avec vidéo